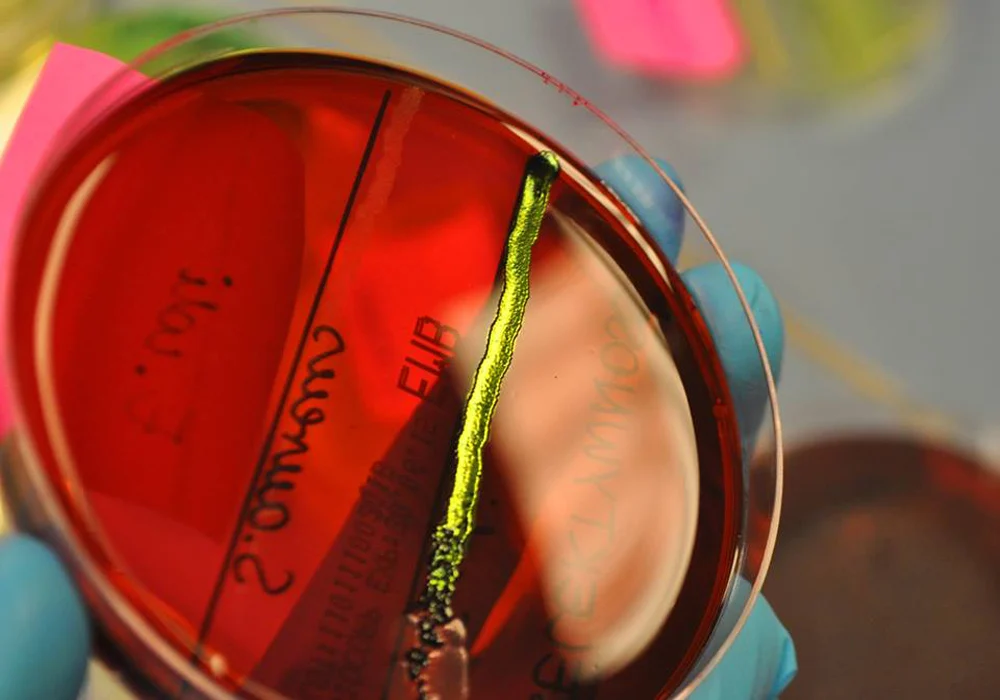

Bursztyn nas uleczy?
Dobre pytanie (śmiech). To zależy z czego…
A z czego nas uleczy?
Chciałoby się, żeby uleczył nas ze wszystkiego, jak kiedyś w to wierzono, albo chociaż z jednego schorzenia, ale za to poważnego. Z ludowych przekazów wynika, że bursztyn stosowano właściwie na wszelkie dolegliwości – na zapalenia dróg oddechowych, bóle głowy i brzucha, w czasach starożytnych wierzono, że odpędza złe moce, a w nowożytnych – że minimalizuje skutki palenia tytoniu i leczy kaca. Sporo tego… (śmiech). Nie da się jednak zbadać wszystkich tych opcji od razu, dlatego ja skupiłem się na tym, do czego miałem najprostszy dostęp, a mianowicie na działaniu bakteriobójczym. Badania potwierdziły to założenie.
Z wiedzy ludowej wynika, że bursztyn ma właściwości lecznicze, wszyscy słyszeli o „działającej cuda” nalewce bursztynowej, ale nie ma na to wszystko dowodów naukowych. Przez długie lata naukowcy omijali bursztyn. Co było dla Ciebie takiego fascynującego w bursztynie, że zdecydowałeś się rozpocząć badania?
Właśnie od tej nalewki zaczęło się moje zainteresowanie bursztynem – w 2. klasie liceum na obozie biologicznym prowadzonym przez specjalizującą się w badaniach nad inkluzjami w bursztynie bałtyckim dr. Elżbietę Sontag wywiązała się dyskusja o właściwościach leczniczych nalewek i bursztynu w ogóle. Zdziwiło mnie, że tyle się o tym mówi i pisze, a mimo to nie istnieją na ten temat żadne wiarygodne, współczesne opracowania naukowe. A te, które istnieją, są trochę na pograniczu szarlatanerii, więc raczej nikt nie traktuje ich poważnie… Dostrzegłem więc dużą lukę badawczą, którą postanowiłem wypełnić.
Read also: Co warto wiedzieć o inkluzjach – rozmowa z Elżbietą Sontag
Są też wyniki badań prowadzonych dekadę temu przez specjalistów z Wydziału Chemicznego Politechniki Warszawskiej i Wyższej Szkoły Zawodowej Kosmetyki i Pielęgnacji Zdrowia, którzy sprawdzali możliwości zastosowania bursztynu w branży kosmetycznej.
To jest bardziej praca przeglądowa na temat właściwości bakteriobójczych bursztynu niż wyniki badań, ponieważ zespół ten nie prowadził badań laboratoryjnych nad wpływem bursztynu na bakterie. Badacze zapoznali się z publikacjami mówiącymi o składzie bursztynu i potwierdzającymi bakteriobójcze działanie zawartych w nim substancji. Problem jednak w tym, że w bursztynie występuje kilkaset różnych substancji i nie wiadomo, co jest substancją aktywną, czy występuje ona w bursztynie w wystarczającej ilości oraz czy działa sama, czy też w połączeniu z innymi substancjami. Z tego opracowania wynikało, że w bursztynie potencjalnie jest kilkadziesiąt substancji, które w czystej formie mają działanie bakteriobójcze o bardzo szerokim spektrum, tj. zabijają wiele różnych mikroorganizmów. I to jest właśnie zagadnienie, którym i ja się zajmuję od kilku lat. Z badań, które dotychczas przeprowadziłem w laboratorium, wynika niezbicie, że z bursztynu da się wyizolować substancje wykazujące właściwości bakteriobójcze, jednak są to obserwacje w dużej mierze odmienne od danych przedstawionych we wspomnianej publikacji przeglądowej. Teraz pozostaje dojść do tego, co dokładnie działa.

Czym się różnią Twoje badania od tych dotychczasowych?
W laboratorium wyszliśmy z oczywistego założenia, że większość oddziaływań biologicznych zachodzi w roztworze. Oznacza to, że pewne substancje trzeba wprowadzić do roztworu – kłopot w tym, że bursztyn się w niczym całkowicie nie rozpuszcza. A nam zależało na względnie łagodnym rozpuszczalniku, który umożliwi badania biologiczne. Na początku wypróbowaliśmy całą serię rozpuszczalników organicznych i sprawdzaliśmy wpływ tych ekstraktów na bakterie – oczywiście dbając o to, by sam rozpuszczalnik ich nie zabił. Wygląda to tak, że bakterie rosną w laboratorium na pożywce na szalce Petriego na takiej warstewce jak galaretka – do tej „galaretki” najprościej dodać badany ekstrakt w odpowiednim stężeniu i sprawdzić, czy bakterie będą na tym dalej rosły i się rozwijały. Jeśli nie, można przenieść badania do roztworu i przeprowadzić bardziej dokładne oznaczenia. To są wstępne badania – od razu widać, czy coś działa bakteriobójczo, czy nie. Schody zaczynają się, kiedy chcemy badać mechanizm działania, bo ten badany ekstrakt trzeba podzielić chemicznie na frakcje o mniejszej ilości składników i każdą frakcję oddzielnie przebadać – aż się dojdzie do frakcji, w których mamy kilka związków albo jeden. Obecnie jesteśmy na etapie rozdziałów chemicznych – to najbardziej wymagający etap technicznie i finansowo. Dużą przeszkodą w kontynuacji tych badań jest fakt, że nie mam jeszcze ukończonych studiów doktoranckich i nie mam własnego laboratorium, więc trudniej mi pozyskać sensowne finansowanie. Muszę więc korzystać z uprzejmości osób zajmujących się nauką lub z małych dofinansowań, które niestety szybko się kończą, a to spowalnia badania. Niemniej jednak udało nam się znaleźć metodę rozdzielenia ekstraktu na mniej skomplikowane frakcje, które zachowują aktywność. To już spory sukces, bo mogło się przecież okazać, że nie będą one wykazywały tej aktywności, albo też że kilkadziesiąt substancji będzie działać tylko jako całość, a po rozdzieleniu nie będzie tego efektu. Na szczęście się udało – efekt jest zachowany i to w różnych frakcjach, co może oznaczać, że da się wyizolować wiele bakteriobójczych substancji. Pytanie tylko, jakie.
Świat mało się interesował badaniami nad bursztynem, a kiedy Ty się pojawiłeś, wszyscy mówili o bursztynie w kontekście Twoich badań.
Myślę, że nie bez wpływu na to zainteresowanie był mój wiek – kiedy zaczynałem te badania, miałem 17 lat, zaś pierwsze efekty w postaci prezentacji wyników na konferencji były już w kolejnym roku. Ponadto projekt wychodzi z badań empirycznych ekstraktu, podczas gdy wcześniejsze badania, choćby te warszawskie, opierały się na przeglądzie literatury. Badacze zebrali dużo danych, ale niestety nie wynika z nich, czy rzeczywiście konkretnie te substancje mogą odpowiadać za działanie bakteriobójcze i czy da się je wyekstrahować w odpowiednim stężenie. Ja pokazałem, że rzeczywiście efekt zachodzi i da się go zaobserwować. Tego nikt wcześniej nie udowodnił na podstawie badań w laboratorium.
W bursztynie musi być jednak niesamowity potencjał, skoro świat się tak mocno tymi badaniami interesuje – zostałeś nawet zaproszony do Instytutu Weizmanna.
Pierwszy raz pojechałem na krótki wyjazd studyjny do Instytutu Weizmanna w Izraelu w 2016 roku w ramach nagrody w Konkursie Explory. W kolejnym roku był to już dwumiesięczny staż. Poznałem tam wiele doświadczonych naukowo i pomocnych osób, które udzieliły mi technicznych i praktycznych rad dotyczących projektu. Wszystko rozwinęło się tak, że obecnie jestem magistrantem w grupie zajmującej się biologią strukturalną. Zdobywam niezbędną wiedzę, aby za jakiś czas być w stanie rozwikłać zagadkę efektu, który udało mi się zaobserwować w związku z bursztynem.
Potencjał bursztynu jest rzeczywiście ogromny. Na podstawie przeprowadzonych badań wykazałem, że uzyskane z bałtyckiego bursztynu oraz innych żywic kopalnych substancje czynne mogłyby zwalczać chorobotwórcze bakterie takie jak np. lekooporne szczepy gronkowca złocistego, nie szkodząc pożytecznym mikroorganizmom jelitowym. Kto wie, być może uda się także potwierdzić, że bursztyn działa jak naturalny antybiotyk…? Ale do tego jeszcze długa droga i wiele badań. Dla bursztynu jest także wiele zastosowań w kosmetyce, np. jako naturalny konserwant. Ma to o tyle duże znaczenie, że szczególnie w kosmetykach naturalnych trudno jest znaleźć substancję naturalnego pochodzenia, która działa jak konserwant i zabija bakterie. Niewykluczone są także zastosowania przemysłowe w chemii materiałowej – jeśli będziemy już wiedzieli, jak ta bakteriobójcza cząsteczka dokładnie wygląda.
Jak na obecnym etapie można wykorzystywać Twoje osiągnięcia?
Na tym etapie moich badań można wprowadzić do kosmetyków ekstrakt bursztynowy pozyskany w sposób naturalny. Jest to o tyle przełomowe, że – na ile się zorientowałem – zdecydowana większość oferowanych na rynku polskim kosmetyków wykorzystuje ekstrakt z bursztynu bałtyckiego zakupiony w Chinach, który z bursztynem bałtyckim nie ma nic wspólnego. Zbadałem w laboratorium jeden z ekstraktów azjatyckiego pochodzenia i okazało się, że jest to niewiele więcej niż woda z konserwantem, a zapach bursztynu jest po prostu sztucznym dodatkiem zapachowym, albo nie ma go wcale. Chciałbym jednak podkreślić, że zdecydowana większość nie oznacza wszystkich firm oferujących bursztynowe kosmetyki – są oczywiście i takie, które podchodzą do tematu bardzo profesjonalnie i odpowiedzialnie. Ale, co naturalne, cena takich rzetelnie przygotowanych kosmetyków jest wtedy również o wiele wyższa.
Będzie przełom w kosmetyce?
Nie tak szybko, niestety. Problemem jest dostępność surowca bursztynowego, z którego można by pozyskiwać ekstrakt – o to rozbijają się obecnie moje rozmowy z dużymi producentami kosmetyków. Rozważamy różne scenariusze, np. na ile wystarczy surowca, jeśli zaczniemy produkować ekstrakt w dużych ilościach, i jak to może wpłynąć na rynek bursztynu. Nie da się wykluczyć, że ceny surowca bursztynowego wzrosną, co pociągnie za sobą wzrost cen ekstraktu, a co za tym idzie i kosmetyków z jego zawartością. Konsekwencje takiego możliwego wzrostu cen odczułby również rynek jubilerski w Polsce i na świecie – nawet jeśli ekstrakt można wyprodukować z najmniejszych frakcji bursztynu, nieprzydatnych w jubilerstwie. Dodam, że mówimy tu o naprawdę poważnych ilościach – np. 100 ton ekstraktu rocznie, do których wyprodukowania potrzeba ok. 200 ton surowca. Na tym etapie zbyt dużo jest niewiadomych i zbyt wiele zagrożeń, dlatego szukamy substancji aktywnej i sprawdzamy możliwości opracowania skutecznej metody syntezy sztucznej. Ekstrakt pozyskiwany z naturalnego surowca pozostaje więc interesującą opcją głównie dla małych firm produkujących naturalne kosmetyki – małe zamówienia nie powinny doprowadzić do zawirowań na rynku bursztynu.
Pytanie, czy da się to kontrolować.
Ryzyko jest zbyt duże. Zysk z wprowadzenia naturalnego konserwantu być może nie jest wart ponoszonego ryzyka poważnego wzrostu cen lub wręcz braku surowca. Więc jeśli chodzi o szersze zastosowanie w branży kosmetycznej, trzeba poczekać, aż uda się znaleźć i zsyntetyzować go sztucznie. Mam nadzieję, że się to uda – pracuję nad tym. Obecnie nawiązałem współpracę ze specjalistami z Gdańska, mieliśmy zaplanowane prace chromatograficzne, ale wszystko pokrzyżowała pandemia koronawirusa. Mam nadzieję, że mimo to jeszcze w tym roku będziemy mieć więcej konkretów.
Igor Kaczmarczyk – 24-letni naukowiec, student Uniwersytetu Jagiellońskiego i Instytutu Weizmanna, twórca innowacyjnego projektu Amber Laboratories. Trzykrotny laureat konkursu dla młodych naukowców E(x)plory, laureat Konkursu Prac Młodych Naukowców UE.
Na zdjęciu: Ekstrakty bursztynowe oraz surowiec użyty do badań. Fot. Igor Kaczmarczyk
Recommended:
Bursztyn w kosmetyce – rozmowa z Katarzyną Pytkowską
Aktywność biologiczna bursztynu – mit czy rzeczywistość?